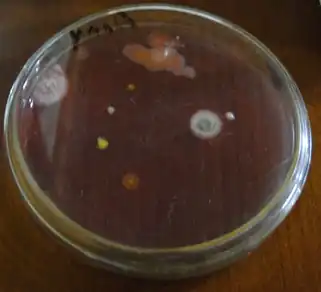

Rhizobium
| Rhizobium | ||
|---|---|---|
![]() Agrobacterium tumefaciens | ||
| Taxonomía | ||
| Dominio: | Bacteria | |
| Filo: | Pseudomonadota | |
| Clase: | Alphaproteobacteria | |
| Orden: | Rhizobiales | |
| Familia: | Rhizobiaceae | |
| Género: |
Rhizobium Frank, 1889 | |
| Especie tipo | ||
| Rhizobium leguminosarum | ||
| Especies | ||
García Fraile et al. 2007
R. cellulosilyticum | ||
Rhizobium es un género de bacterias gram-negativas del suelo que fijan nitrógeno atmosférico.[1] Pertenece a un grupo de bacterias fijadoras de nitrógeno que se denominan colectivamente rizobio. Viven en simbiosis con determinadas plantas (como por ejemplo las leguminosas) en su raíz, después de un proceso de infección inducido por la propia planta mediante la secreción de lectina, a las que aportan el nitrógeno necesario para que la planta viva y esta a cambio le da cobijo. Más específicamente, la condición de simbiosis viene dada por la formación de una molécula de transporte de oxígeno, equivalente a la hemoglobina, llamada leghemoglobina. Solo se puede sintetizar cuando los dos organismos se encuentran en simbiosis; por parte de la bacteria se sintetiza el grupo hemo de dicha molécula, y por parte de la planta se sintetiza la apoproteína. Así, mediante la nueva molécula formada, se puede llevar a cabo el transporte de oxígeno necesario para el metabolismo de la bacteria (y así poder fijar el nitrógeno requerido por la planta).
Historia
La fijación biológica de nitrógeno es conocida desde hace ya mucho tiempo. Mucho antes de conocer esta relación simbiótica Rhizobium-leguminosa y sus beneficios, se hacía uso de las leguminosas para mejorar la fertilidad de los terrenos para futuros cultivos a través de técnicas como "barbecho " o de cultivo rotatorio conocido con el nombre de "abono verde". Jean-Baptiste Boussingault, un reconocido químico francés, dio los primeros indicios acerca de la incorporación de nitrógeno por parte de los tréboles y las judías. Pero fueron Hellriegel y Wilfarth (1886-1888) quienes establecieron la relación entre los nódulos de las leguminosas y la fijación de nitrógeno. Archivado el 12 de junio de 2013 en Wayback Machine. Por otro lado, Beijerinck, uno de los más grandes microbiólogos, fue el primero en aislar y cultivar un microorganismo de los nódulos de legumbres en 1888. Él lo llamó el Bacillus radicicola (bacilo radicícola), que ahora es colocado en el Manual de Bergey de Bacteriología Determinativa bajo el género Rhizobium.
Características
Las bacterias Rhizobium son organismos de vida libre que habitan en la rizosfera y se alimenta de los restos de organismos muertos. Estas contienen un plásmido que codifica información que es vital para la infección y la nodulación de la planta hospedadora correspondiente.
Son bacilos móviles, Gram-negativos, con dos capas de pared celular (la primera capa está hecha por carbohidratos y proteínas, y la segunda capa por lípidos y carbohidratos), procariotas, aerobios (necesita oxígeno para crecer), móviles (al hacerse el test de motilidad, el agar se vuelve amarillo y no de su color original —morado—), beta (digiere la hemoglobina), crece casi en cualquier temperatura, pero su desarrollo es óptimo a una temperatura de 25 °C (77 °F), sus dimensiones son de 0.5-0.9 x 1.2-3.0 µm, y cuenta con flagelos.
Filogenia
La taxonomía que actualmente es aceptada está basada en el 'List of Prokaryotic names with Standing in Nomenclature' y en el National Center for Biotechnology Information, y la filogenia está basada en el 16S rRNA-based LTP release 106 por 'The All-Species Living Tree Project'.
| ||||||||||||||||||||||||||||||||||||||||||||||||||||||||||||||||||||||||||||||||||||||||||||||||||||||||||||||||||||||||||||||||||||||||||||||||||||||||||||||||
Simbiosis con leguminosas
La asociación Rhizobium-leguminosa es uno de los mejores ejemplos de una auténtica simbiosis, pues las plantas que crecen en suelos carentes de nitrógeno (o con niveles muy reducidos) se ven beneficiadas por la fijación realizada por las bacterias, y las plantas brindan a estas un ambiente que las protege y nutre.
Etapas de formación de nódulos
- Reconocimiento: tanto la planta como la bacteria deben reconocer al socio adecuado. Esto se realiza gracias a que las raíces de las leguminosas segregan materiales orgánicos que estimulan el crecimiento microbiano en la rizosfera (no es exclusivo de los rizobios). Si en el suelo hay presencia de rizobios, estos se desarrollarán hasta construir poblaciones densas. Es así que el primer paso de la formación del nódulo es la adherencia de la bacteria a los pelos radicales de la planta correspondiente, y esto es mediado por la ricadesina, una proteína específica de adherencia presente en la superficie de toda bacteria Rhizobium. Esta actúa al unirse a complejos de calcio que se encuentran en la superficie de los pelos radicales. También existen otras sustancias que forman parte en esta adherencia planta-bacteria, como, por ejemplo, las lectinas, que se unirán a distintos oligosacáridos de la superficie bacteriana.
- Excreción de los factores nod por la bacteria: en primer lugar, las células de la bacteria penetran el pelo radical por su extremo, y la bacteria excreta unas sustancias denominadas factores nod, los cuales causan que el pelo radicado se rice. En esta sustancia se encuentran los genes que dirigirán posteriormente las etapas específicas de la nodulación. Estos son transmitidos atreves de plásmidos de gran tamaño, llamados plásmidos Sym, los cuales contienen genes de especificidad, lo cual determina qué cepa de Rhizobium se unirá a cierta planta hospedadora. Es así que además de los genes nod comunes, están los específicos para cada especie de Rhizobium. Por otro lado, los genes nod participan de la producción de los ya mencionados factores nod (oligosacáridos), los cuales desencadenan la división celular cortical de la planta para formar así el nódulo.
- Invasión: la bacteria procede a invadir el pelo radical e inducen a la planta a formar un tubo de celulosa conocido como tubo de infección, dentro del cual se multiplicaran los rizobios.
- Desplazamiento: las bacterias se desplazan hacia la raíz a través del tubo de infección y allí la infección alcanza a las células contiguas a los pelos radicales, y los factores nod estimulan la división celular de las células vegetales, formando finalmente el nódulo.
- Aparición de los bacteroides: dentro de las células de las plantas, las bacterias Rhizobium se multiplican y se convierten en formaciones ramificadas e hinchadas, y es allí donde aparecen los bacteroides, células bacterianas deformes necesarias para la fijación de nitrógeno. Estos quedan rodeados por porciones de la membrana vegetal para formar unas estructuras llamadas simbiosoma, y en el momento en que estas son formadas se da inicio a la fijación de nitrógeno.
- División continua de células: luego de la formación del nódulo radical maduro, las células bacterianas y vegetales deben permanecer en continua división.
Leghemoglobina
Ni las leguminosas, ni la bacteria Rhizobium pueden fijar nitrógeno en condiciones de vida libre, solo se logra en el momento en que estas interactúan en una simbiosis. Aunque en un cultivo axénico con condiciones microfilicas controladas la bacteria puede fijar nitrógeno atmosférico, esta necesita oxígeno para generar energía y así fijar nitrógeno, pero su nitrogenasa es inactivada por el oxígeno. Por otro lado, en el nódulo se encuentran las concentraciones de oxígeno exactas, las cuales son controladas por la leghemoglobina, proteína que se une al oxígeno. Esta proteína es de color rojo, ya que contiene hierro, y siempre está presente en nódulos sanos fijadores de nitrógeno. Su formación es inducida por la interacción planta-bacteria, ya que cada una por aparte es incapaz de sintetizarla. Esta funciona como un tapón de oxígeno, que mantiene la concentración de este bajo, pero constante. La relación existente en el nódulo de leghemoglobina y oxígeno es 10 000:1.
Grupos de inoculación cruzada
Los grupos de inoculación cruzada son los grupos de cepas de Rhizobium que solo infectan a un determinado grupo de especies próximas a las leguminosas. El que una cepa pueda infectar a una determinada leguminosa, no significa que aparezcan los nódulos fijadores de nitrógeno. Esa capacidad está determinada por los genes presentes en las bacterias. Se identifica a las cepas inefectivas porque producen nódulos de menor tamaño, blancuzcos y sin la capacidad fijadora de nitrógeno, mientras que las cepas efectivas forman nódulos mayores, rojizos y capaces de fijar nitrógeno. Es así que en conclusión, ya que existen diferentes variedades de bacterias Rhizobium, cada una tiene la capacidad de hacer simbiosis con una leguminosa determinada. La tabla a continuación muestra ciertas plantas hospedadoras con su correspondiente grupo de inoculación cruzada:
| Planta hospedadora | Cepa de la bacteria Rhizobium |
|---|---|
| Guisante | Rhizobium leguminosarum biovar viciae |
| Judía | Rhizobium Leguminosarum biovar phaseoli |
| Judía | Rhizobium tropici |
| Loto | Mesorhizobium loti |
| Trébol | Rhizobium lehuminosarum biovar trifoli |
| Alfalfa | Sinorhizobium melitoti |
| Soja | Bradyrhizobium japonicum |
| Soja | Bradyrhizobium elkanii |
| Soja | Rhizobium fredii |
| Sesbania rostrata (leguminosa tropical) | Azorhizobium caulinodans |
Importancia en la agricultura
La simbiosis entre la bacteria Rhizobium y las leguminosas tiene una gran importancia tanto en la agricultura, como en el medio ambiente. En cuanto a la agricultura, se dice que se ve beneficiada, ya que causa un aumento significativo de nitrógeno combinado en suelos desnudo y que carecen de este. Además, las leguminosas, parte esencial de la agricultura, se ven favorecidas al poder crecer en zonas donde otras plantas no podrían. Por otro lado, ya que el nitrógeno es uno de los nutrientes esenciales limitados para el crecimiento de las plantas, esta simbiosis aumenta el nivel de fijación del nitrógeno atmosférico, aumentando así la producción agrícola. También beneficiaria a la agricultura económicamente, pues debido a que muchas industrias agrícolas dependen de la cosecha de leguminosas, el hecho de que estas puedan crecer sin abonos nitrogenados (pues la bacteria los remplazaría) hace que sea posible el ahorrarse millones en abonos.
En cuanto a la parte ambiental, los fertilizantes son uno de los principales causantes del deterioro ambiental, pues causan la eutrofización de masas de aguas, la erosión de suelos y generación de lluvias ácidas. Estas bacterias fijadoras de nitrógeno pueden ser utilizadas en reemplazo de los fertilizantes nitrogenados para incrementar el crecimiento de las leguminosas, acabando con los problemas ambientales que se han venido causando.

Investigación
La bacteria Rhizobium forma una relación simbiótica con ciertas plantas, como por ejemplo con las legumbres. El Rhizobium fija el nitrógeno del aire en la planta en forma de amoníaco, el que actúa como un fertilizante natural para esta. La investigación actual está siendo dirigida por microbiólogos de Servicio de Investigación Agrícola para descubrir un modo de utilizar la fijación de nitrógeno biológica de la bacteria Rhizobium para favorecer la agricultura. Esta investigación busca trazar un mapa genético de varias especies de Rhizobium con las especies de plantas respectivas con las que realiza simbiosis, como la alfalfa o la soja. El objetivo de esta investigación es el de aumentar la productividad de las plantas sin necesidad de usar fertilizantes (cita requerida).
Véase también
Bibliografía
- Madigan, M., Martinko, J., & Parker, J. (2003). Brock – biología de los microorganismos. (10a ed., pp. 654 - 684).
- Prescott, L. (2002). Microbiology. (5a ed., pp. 441-446). McGraw-Hill Science
- Tarrant, A. (n.d.). Rhizobium leguminosarum. En Modmedmicrobes
- Downie, A., & Brewin, N. (n.d.). The rhizobium - legume symbiosis. En Molecular Microbiology
- Lecture 10: Background (rhizobia). (13 de octubre de 2009). en NRE 509
- Cuadrado, B., Rubio, G. & Santos , W. (2009). Caracterización de cepas de rhizobium y bradyrhizobium (con habilidad de nodulación) seleccionados de los cultivos de fríjol caupi (vigna unguiculata) como potenciales bioinóculos. Revista Colombiana de Ciencias Químico Farmacéuticas, 38(1), en (enlace roto disponible en Internet Archive; véase el historial, la primera versión y la última). Revista Colombiana de Ciencias Químico Farmacéuticas - Universidad Nacional de Colombia, Bógota.
Referencias
- ↑ Sawada H, Kuykendall LD, Young JM (2003). «Changing concepts in the systematics of bacterial nitrogen-fixing legume symbionts». J. Gen. Appl. Microbiol. 49 (3): 155-79. PMID 12949698.
- 1 2 These species were formerly classified in the genus Agrobacterium.
- ↑ This is the type species for the genus.
- ↑ Arthrobacter viscosus is currently classified in the Micrococcaceae. (See Arthrobacter).
